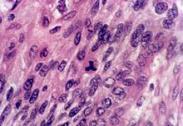

-
肝血管肉瘤
628健康網為您分享有關肝血管肉瘤的癥狀,肝血管肉瘤的治療方法,肝血管肉瘤的預防知識,肝血管肉瘤的癥狀圖片,肝血管肉瘤...
-
肝動脈瘤
628健康網為您分享有關肝動脈瘤的癥狀,肝動脈瘤的治療方法,肝動脈瘤的預防知識,肝動脈瘤的癥狀圖片,肝動脈瘤吃什么藥,肝...
-
肝棘球蚴病
628健康網為您分享有關肝棘球蚴病的癥狀,肝棘球蚴病的治療方法,肝棘球蚴病的預防知識,肝棘球蚴病的癥狀圖片,肝棘球蚴病...
-
肝錯構瘤
628健康網為您分享有關肝錯構瘤的癥狀,肝錯構瘤的治療方法,肝錯構瘤的預防知識,肝錯構瘤的癥狀圖片,肝錯構瘤吃什么藥,肝...
-
老年人膽囊癌
628健康網為您分享有關老年人膽囊癌的癥狀,老年人膽囊癌的治療方法,老年人膽囊癌的預防知識,老年人膽囊癌的癥狀圖片,老...
-
膽囊平滑肌肉瘤
628健康網為您分享有關膽囊平滑肌肉瘤的癥狀,膽囊平滑肌肉瘤的治療方法,膽囊平滑肌肉瘤的預防知識,膽囊平滑肌肉瘤的癥狀...
-
肝上皮樣血管內皮細胞瘤
628健康網為您分享有關肝上皮樣血管內皮細胞瘤的癥狀,肝上皮樣血管內皮細胞瘤的治療方法,肝上皮樣血管內皮細胞瘤的預防...
-
老年人原發性肝癌
628健康網為您分享有關老年人原發性肝癌的癥狀,老年人原發性肝癌的治療方法,老年人原發性肝癌的預防知識,老年人原發性肝...
-
膽囊良性腫瘤
628健康網為您分享有關膽囊良性腫瘤的癥狀,膽囊良性腫瘤的治療方法,膽囊良性腫瘤的預防知識,膽囊良性腫瘤的癥狀圖片,膽...
-
環狀胰腺
628健康網為您分享有關環狀胰腺的癥狀,環狀胰腺的治療方法,環狀胰腺的預防知識,環狀胰腺的癥狀圖片,環狀胰腺吃什么藥,環...
-
膽道蛔蟲病與肝蛔蟲病
628健康網為您分享有關膽道蛔蟲病與肝蛔蟲病的癥狀,膽道蛔蟲病與肝蛔蟲病的治療方法,膽道蛔蟲病與肝蛔蟲病的預防知識...
-
肝纖維板層癌
628健康網為您分享有關肝纖維板層癌的癥狀,肝纖維板層癌的治療方法,肝纖維板層癌的預防知識,肝纖維板層癌的癥狀圖片,肝...
-
膽腸內引流術后內疝
628健康網為您分享有關膽腸內引流術后內疝的癥狀,膽腸內引流術后內疝的治療方法,膽腸內引流術后內疝的預防知識,膽腸內引...
-
肝小靜脈閉塞癥
628健康網為您分享有關肝小靜脈閉塞癥的癥狀,肝小靜脈閉塞癥的治療方法,肝小靜脈閉塞癥的預防知識,肝小靜脈閉塞癥的癥狀...
-
膽道華支睪吸蟲病
628健康網為您分享有關膽道華支睪吸蟲病的癥狀,膽道華支睪吸蟲病的治療方法,膽道華支睪吸蟲病的預防知識,膽道華支睪吸蟲...
-
肝臟外傷
628健康網為您分享有關肝臟外傷的癥狀,肝臟外傷的治療方法,肝臟外傷的預防知識,肝臟外傷的癥狀圖片,肝臟外傷吃什么藥,肝...
-
肝動脈閉塞
628健康網為您分享有關肝動脈閉塞的癥狀,肝動脈閉塞的治療方法,肝動脈閉塞的預防知識,肝動脈閉塞的癥狀圖片,肝動脈閉塞...
-
肝臟類癌
628健康網為您分享有關肝臟類癌的癥狀,肝臟類癌的治療方法,肝臟類癌的預防知識,肝臟類癌的癥狀圖片,肝臟類癌吃什么藥,肝...
-
肝血管平滑肌脂肪瘤
628健康網為您分享有關肝血管平滑肌脂肪瘤的癥狀,肝血管平滑肌脂肪瘤的治療方法,肝血管平滑肌脂肪瘤的預防知識,肝血管平...
-
門靜脈血栓形成
628健康網為您分享有關門靜脈血栓形成的癥狀,門靜脈血栓形成的治療方法,門靜脈血栓形成的預防知識,門靜脈血栓形成的癥狀...
-
類癌綜合征
628健康網為您分享有關類癌綜合征的癥狀,類癌綜合征的治療方法,類癌綜合征的預防知識,類癌綜合征的癥狀圖片,類癌綜合征...
-
生長激素釋放抑制素瘤
628健康網為您分享有關生長激素釋放抑制素瘤的癥狀,生長激素釋放抑制素瘤的治療方法,生長激素釋放抑制素瘤的預防知識...
-
先天性肝內膽管囊狀擴張癥
628健康網為您分享有關先天性肝內膽管囊狀擴張癥的癥狀,先天性肝內膽管囊狀擴張癥的治療方法,先天性肝內膽管囊狀擴張癥...
-
慢性膽管炎
628健康網為您分享有關慢性膽管炎的癥狀,慢性膽管炎的治療方法,慢性膽管炎的預防知識,慢性膽管炎的癥狀圖片,慢性膽管炎...
-
急性結石性膽囊炎
628健康網為您分享有關急性結石性膽囊炎的癥狀,急性結石性膽囊炎的治療方法,急性結石性膽囊炎的預防知識,急性結石性膽囊...
-
胰高血糖素瘤
628健康網為您分享有關胰高血糖素瘤的癥狀,胰高血糖素瘤的治療方法,胰高血糖素瘤的預防知識,胰高血糖素瘤的癥狀圖片,胰...
-
十二指腸腺癌
628健康網為您分享有關十二指腸腺癌的癥狀,十二指腸腺癌的治療方法,十二指腸腺癌的預防知識,十二指腸腺癌的癥狀圖片,十...
-
小兒肝腫瘤
628健康網為您分享有關小兒肝腫瘤的癥狀,小兒肝腫瘤的治療方法,小兒肝腫瘤的預防知識,小兒肝腫瘤的癥狀圖片,小兒肝腫瘤...
-
棘球蚴病
628健康網為您分享有關棘球蚴病的癥狀,棘球蚴病的治療方法,棘球蚴病的預防知識,棘球蚴病的癥狀圖片,棘球蚴病吃什么藥,棘...
-
胰腺多肽瘤
628健康網為您分享有關胰腺多肽瘤的癥狀,胰腺多肽瘤的治療方法,胰腺多肽瘤的預防知識,胰腺多肽瘤的癥狀圖片,胰腺多肽瘤...
-
外傷性膽管損傷
628健康網為您分享有關外傷性膽管損傷的癥狀,外傷性膽管損傷的治療方法,外傷性膽管損傷的預防知識,外傷性膽管損傷的癥狀...
-
小兒戈謝病
628健康網為您分享有關小兒戈謝病的癥狀,小兒戈謝病的治療方法,小兒戈謝病的預防知識,小兒戈謝病的癥狀圖片,小兒戈謝病...
-
胰石癥
628健康網為您分享有關胰石癥的癥狀,胰石癥的治療方法,胰石癥的預防知識,胰石癥的癥狀圖片,胰石癥吃什么藥,胰石癥怎么治...
-
胰腺瘺
628健康網為您分享有關胰腺瘺的癥狀,胰腺瘺的治療方法,胰腺瘺的預防知識,胰腺瘺的癥狀圖片,胰腺瘺吃什么藥,胰腺瘺怎么治...
-
小兒肝母細胞瘤
628健康網為您分享有關小兒肝母細胞瘤的癥狀,小兒肝母細胞瘤的治療方法,小兒肝母細胞瘤的預防知識,小兒肝母細胞瘤的癥狀...
-
胰腺囊腺癌
628健康網為您分享有關胰腺囊腺癌的癥狀,胰腺囊腺癌的治療方法,胰腺囊腺癌的預防知識,胰腺囊腺癌的癥狀圖片,胰腺囊腺癌...
-
胰腺膿腫
628健康網為您分享有關胰腺膿腫的癥狀,胰腺膿腫的治療方法,胰腺膿腫的預防知識,胰腺膿腫的癥狀圖片,胰腺膿腫吃什么藥,胰...
-
先天性膽管囊狀擴張
628健康網為您分享有關先天性膽管囊狀擴張的癥狀,先天性膽管囊狀擴張的治療方法,先天性膽管囊狀擴張的預防知識,先天性膽...
-
胰島細胞類癌
628健康網為您分享有關胰島細胞類癌的癥狀,胰島細胞類癌的治療方法,胰島細胞類癌的預防知識,胰島細胞類癌的癥狀圖片,胰...
-
血吸蟲病與肝膽疾病
628健康網為您分享有關血吸蟲病與肝膽疾病的癥狀,血吸蟲病與肝膽疾病的治療方法,血吸蟲病與肝膽疾病的預防知識,血吸蟲病...
-
醫源性膽管損傷
628健康網為您分享有關醫源性膽管損傷的癥狀,醫源性膽管損傷的治療方法,醫源性膽管損傷的預防知識,醫源性膽管損傷的癥狀...
-
小兒尼曼-皮克病
628健康網為您分享有關小兒尼曼-皮克病的癥狀,小兒尼曼-皮克病的治療方法,小兒尼曼-皮克病的預防知識,小兒尼曼-皮克病的...
-
胰癰
628健康網為您分享有關胰癰的癥狀,胰癰的治療方法,胰癰的預防知識,胰癰的癥狀圖片,胰癰吃什么藥,胰癰怎么治療,胰癰患者食...
-
胰腺外傷
628健康網為您分享有關胰腺外傷的癥狀,胰腺外傷的治療方法,胰腺外傷的預防知識,胰腺外傷的癥狀圖片,胰腺外傷吃什么藥,胰...
-
小兒槭糖尿病
628健康網為您分享有關小兒槭糖尿病的癥狀,小兒槭糖尿病的治療方法,小兒槭糖尿病的預防知識,小兒槭糖尿病的癥狀圖片,小...
-
原發性肝脂肪肉瘤
628健康網為您分享有關原發性肝脂肪肉瘤的癥狀,原發性肝脂肪肉瘤的治療方法,原發性肝脂肪肉瘤的預防知識,原發性肝脂肪肉...
-
膽管結石
628健康網為您分享有關膽管結石的癥狀,膽管結石的治療方法,膽管結石的預防知識,膽管結石的癥狀圖片,膽管結石吃什么藥,膽...
-
胰多肽瘤
628健康網為您分享有關胰多肽瘤的癥狀,胰多肽瘤的治療方法,胰多肽瘤的預防知識,胰多肽瘤的癥狀圖片,胰多肽瘤吃什么藥,胰...
-
肝門膽管癌
628健康網為您分享有關肝門膽管癌的癥狀,肝門膽管癌的治療方法,肝門膽管癌的預防知識,肝門膽管癌的癥狀圖片,肝門膽管癌...
-
轉移性肝癌
628健康網為您分享有關轉移性肝癌的癥狀,轉移性肝癌的治療方法,轉移性肝癌的預防知識,轉移性肝癌的癥狀圖片,轉移性肝癌...